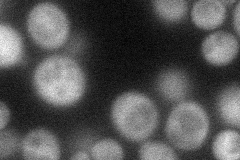
YJR036C
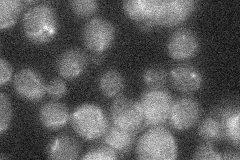
YJR036C
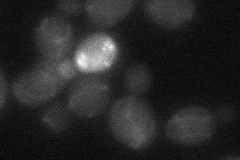
YJR036C

View description
Protein with similarity to hect domain E3 ubiquitin-protein ligases, not essential for viability
Localization:
Intensity:
Fold change:
Significance:
-
C’ GFP library in SD

below threshold16.37 -
N' NOP1pr-GFP in SD
cytosol37.5935 -
N' TEF2pr-mCherry in SD

cytosol20.7416 -
N' NATIVEpr-GFP in SD
below threshold19.9891 -
N' TEF2pr-VC and Cyto-VN in SD
below threshold24.45 -
C’ GFP library in SD+DTT

cytosol18.621.13No -
C’ GFP library in SD+H2O2

cytosol16.731.02No -
C’ GFP library in Starvation Media

cytosol15.930.97No -
C’ GFP library on the background of Pup2-DaMP

below threshold -
C’ GFP library on the background of CCT mutant

below threshold17.36961.06048No
